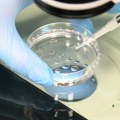
Семена течност донора са геном који изазива рак употребљена за зачеће скоро 200 деце, ББЦ: Коришћена и у Србији

Теорија о 10.000 корака дневно за здравији живот настала је 1964. године: Да ли је истина или мит?
Данас 24.02.2023 | ДанасОнлине

Савети у вези са здрављем налазе се на сваком кораку.
Често је реч о контрадикторним чланцима, који одавно нису релевантни, или имају за циљ прикупљање кликова. То понекад доноси више штете него користи, посебно уколико имате одређене дијагнозе. Препоруке које је прикупио научни часопис Фоцус, који послује у склопу компаније ББЦ, честе су и не представљају новитет, али када се обједине, уочава се како је здрав живот заправо и прилично активан. Проверили смо. Према британском НХС-у, препорука је да се вежба 150